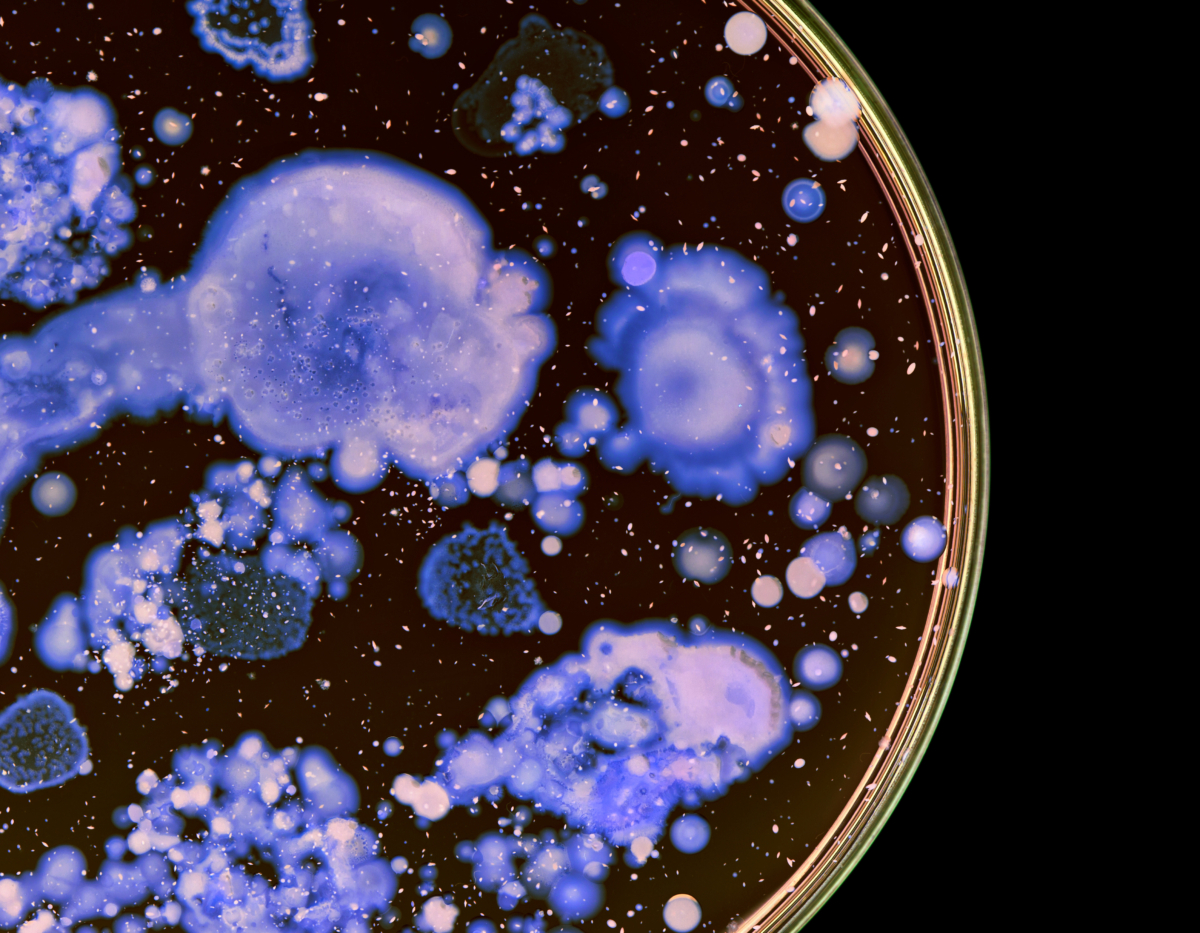
blank

Patrzymy w przyszłość
Innowacje w branży
medycznej
Frontline Biosciences S.A. jest podmiotem wyspecjalizowanym we wspieraniu rozwoju projektów medycznych na różnych poziomach gotowości technologicznej, od pomysłu po rynek.
Dostarczamy spójne i kompleksowe rozwiązania, tak w odniesieniu do pojedynczych przedsięwzięć, jak i długofalowych strategii rozwoju przedsiębiorstw w oparciu o kreowanie i wdrażanie innowacji.Projekty B+R
Dostępne konkursy
Inne dotacje
Dostępne konkursy
Infrastruktura B+R
Dostępne konkursy

O nas
Zespół, misja, wartości
Frontline Biosciences S.A. to zespół ekspertów ukierunkowany na wsparcie rozwoju innowacji w branży medycznej. Łączymy wiedzę z obszaru badań klinicznych i zagadnień regulacyjnych, zapewniając także dostęp do finansowania projektów w postaci instrumentów dotacyjnych oraz wsparcia inwestorów zewnętrznych.
Wiadomości branżowe